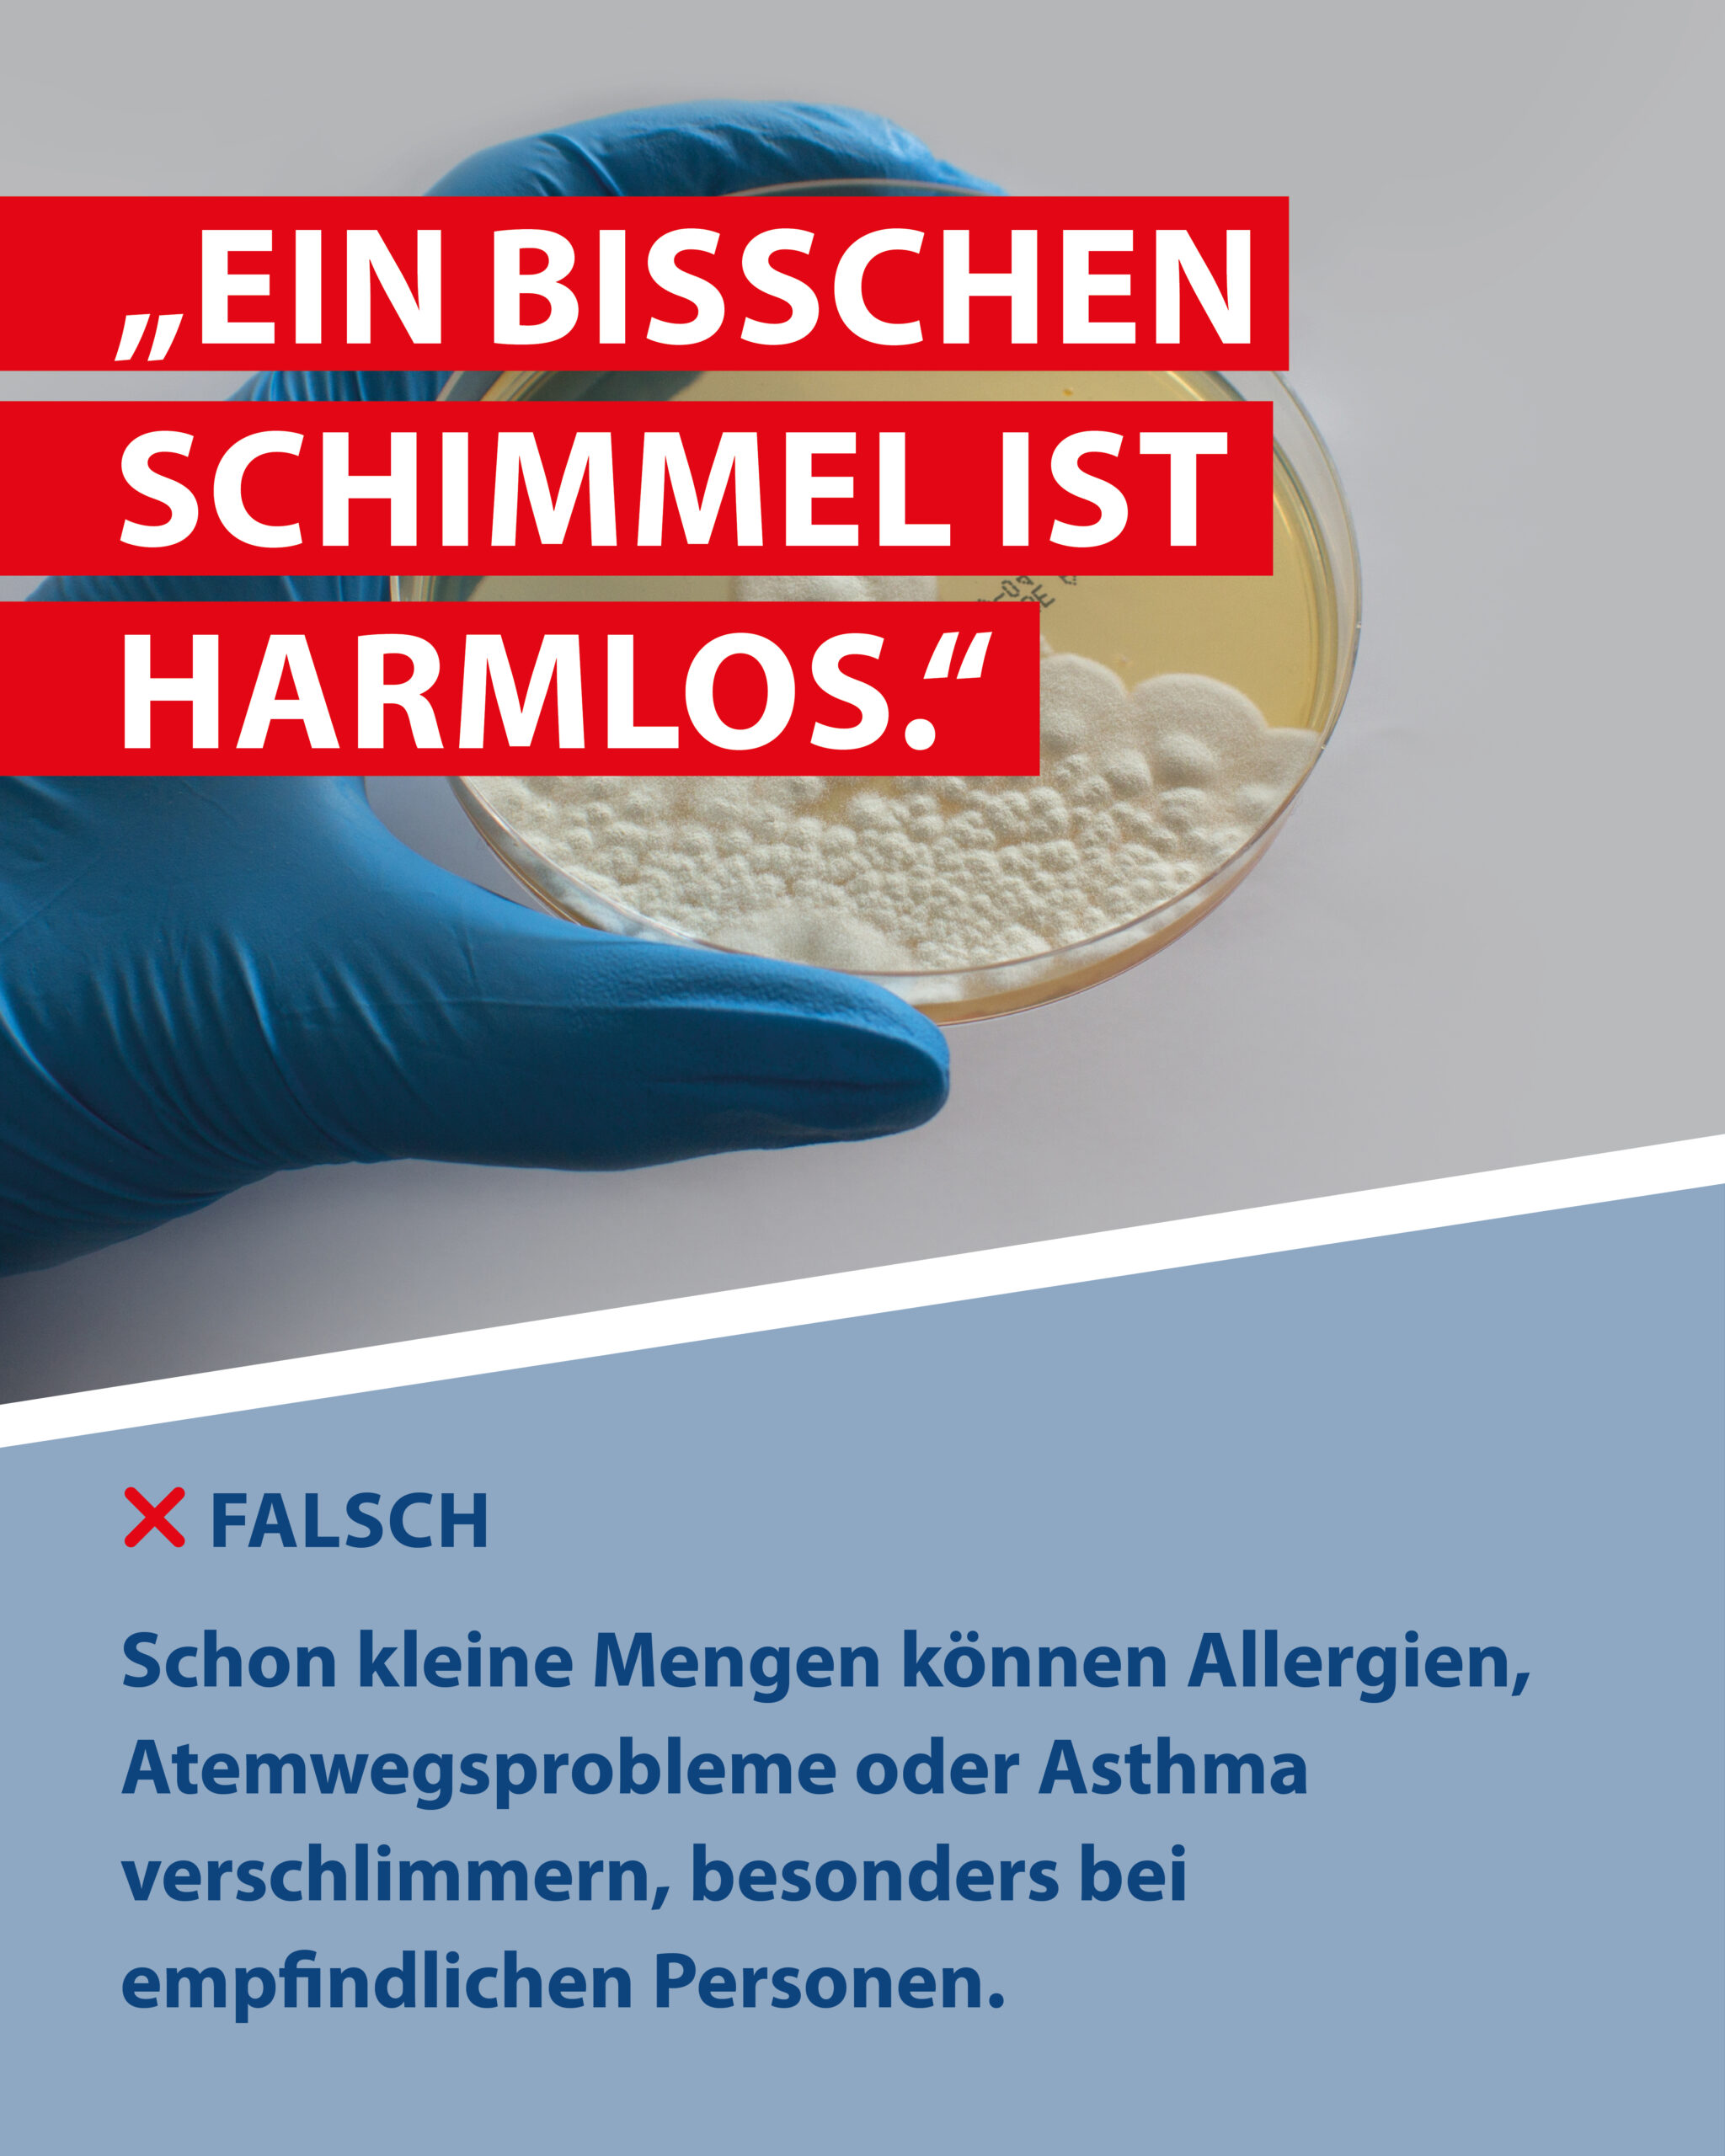

Mythen über Schimmel
Schimmel-Irrtümer und Mythen – Was wirklich stimmt
Schimmel in Innenräumen ist ein Thema, das viele Fragen aufwirft – und leider auch zahlreiche Mythen.
Als Hersteller professioneller Spezialreiniger möchten wir Ihnen helfen, zwischen Fakten und Irrtümern zu unterscheiden.
Unser Ziel ist es, Ihnen Sicherheit, Klarheit und praktikable Lösungen zu bieten.
Warum Schimmel entsteht – die wichtigsten Hintergründe
Schimmel entsteht, wenn drei Faktoren zusammenkommen: Feuchtigkeit, Nährboden und Temperatur.
Häufig liegt die Ursache nicht im sichtbaren Bereich, sondern in der Raumluft oder in baulichen Bedingungen wie Wärmebrücken.
Besonders in modernen, dichten Neubauten kann Feuchtigkeit schlechter entweichen – ein optimaler Nährboden für Schimmel.
Schimmel erkennen – auch wenn er unsichtbar ist
Oft entwickeln sich Schimmelsporen an Orten, die leicht übersehen werden: hinter Schränken, unter Fensterbänken,
in Zimmerecken oder an Kältebrücken. Ein muffiger Geruch, Kondenswasser oder kleine dunkle Punkte können erste Hinweise sein.
Der MELLERUD Schimmel Stopp Schnelltest liefert schnelle Sicherheit.
Die häufigsten Schimmel-Mythen – und was wirklich stimmt

Mythos 1: Schimmel entsteht nur in alten Häusern – falsch
Schimmel kann in jedem Gebäude auftreten – unabhängig vom Baujahr. Besonders moderne Neubauten sind oft stärker betroffen,
da sie sehr luftdicht konstruiert sind. Feuchtigkeit kann dadurch schlechter entweichen und sich in Wohnräumen anreichern.
Wichtig ist daher ein durchdachtes Lüftungs- und Heizverhalten.

Mythos 2: Regelmäßiges Lüften verhindert Schimmel zuverlässig – nicht immer
Lüften ist ein zentraler Baustein der Schimmelprävention, aber nicht die einzige Lösung. Wenn Feuchtigkeitsquellen bestehen –
etwa undichte Rohre, Kondenswasser an kalten Oberflächen oder Wärmebrücken – reicht Lüften allein häufig nicht aus.
Prüfen Sie daher die Ursachen gründlich, bevor Sie zur Beseitigung übergehen.
-entferner
kann hier eine erste, schnelle Soforthilfe sein.
Mythos 3: Ein bisschen Schimmel ist harmlos – falsch
Auch kleine Mengen Schimmel können die Hygiene in Innenräumen beeinträchtigen. Besonders auf empfindlichen Oberflächen oder in Bereichen mit hoher Luftfeuchtigkeit kann er sich schnell ausbreiten. Frühzeitiges Handeln spart Zeit, Aufwand und verhindert größere Schäden. Der Befall kann unter Umständen auch schon größer sein als es optisch erkennbar ist. Grade in Kombi mit wenig Lüften kann von einer erhöhten Sporenbelastung der Raumluft dann auch eine Gesundheitsgefahr ausgehen.
Mit dem MELLERUD Schimmel Vernichter können Sie befallene Stellen zuverlässig behandeln.

Mythos 4: Schimmel tritt nur im Winter auf – falsch
Zwar begünstigt die Heizperiode das Schimmelwachstum besonders stark,
doch auch in Frühling und Herbst können Temperaturunterschiede zu Kondensation führen –
gerade in Badezimmern, Küchen oder Schlafzimmern. Achten Sie auf richtiges Lüften,
konstante Raumtemperaturen und ausreichend Abstand zwischen Möbeln und Außenwänden.

Mythos 5: Schwarzschimmel ist immer der gefährlichste – falsch
Die Farbe allein sagt wenig aus. Schwarzschimmel ist kein spezifischer Pilz, sondern beschreibt lediglich den Farbton.
Jede Schimmelart kann hygienische Probleme verursachen – entscheidend sind Menge, Ort und die individuelle Empfindlichkeit.
Mit dem MELLERUD Schimmel Schnelltest
lässt sich potenzieller Befall schnell überprüfen.
Praktische Tipps unserer Experten
1. Luftfeuchtigkeit zwischen 40–60 % halten
Eine stabile Luftfeuchtigkeit ist der wichtigste Faktor zur Schimmelprävention. Werte unter 40 % trocknen die Raumluft stark aus, während über 60 % ideale Bedingungen für Schimmel schaffen.
So gelingt’s im Alltag:
- Hygrometer nutzen
- Schlafzimmer morgens gut lüften
- Wäsche nicht drinnen trocknen
- Luftentfeuchter in fensterlosen Räumen verwenden
2. Stoßlüften statt Kipplüften – besonders nach dem Duschen oder Kochen
Beim Kippen findet kaum Luftaustausch statt und die angrenzende Wand kühlt aus – ein idealer Ort für Schimmel.
Besser:
- 3–5 Minuten Fenster weit öffnen
- Nach dem Duschen warme Luft schnell rauslassen
- Nach dem Kochen sofort lüften
- Im Winter häufiger, aber kürzer lüften
3. Möbel mit Abstand zur Wand platzieren
Stehen Möbel direkt an kalten Außenwänden, entsteht dahinter kaum Luftzirkulation. Die Temperatur sinkt, Feuchtigkeit kondensiert – Schimmel entsteht.
Unsere Empfehlung:
- 5–10 cm Abstand einhalten
- Große Möbel nicht an Außenwände stellen
- Hinter Heizkörpern Luftzirkulation sicherstellen
4. Feuchte Stellen sofort trocknen – und Ursache prüfen
Egal ob es Kondenswasser am Fenster, ein nasser Badboden oder ein feuchter Fleck an der Wand ist: Feuchtigkeit sollte niemals „stehen bleiben“.
Wichtig:
- Fensterrahmen morgens abwischen
- Duschkabine mit Abzieher trocknen
- Spülbecken und Arbeitsflächen nach dem Kochen oder Abwasch trocknen
- Feuchte Wände nie ignorieren – Ursache lokalisieren
5. Bei wiederholtem Befall Ursachen professionell prüfen lassen
Wenn Schimmel trotz richtiger Reinigung immer wiederkommt, liegt oft eine tieferliegende Ursache vor, z. B.:
- Wärmebrücken/li>
- undichte Fenster
- Feuchtigkeit im Mauerwerk
- schlechter Wandaufbau
- unzureichende Dämmung
Ein Fachmann kann mit Messgeräten (z. B. Thermografie, Feuchtigkeitsanalyse) die Ursache schnell identifizieren.
Frühzeitiges Handeln verhindert größere Schäden und spart langfristig Kosten.
FAQ – Häufige Fragen zu Schimmel
Wie erkenne ich versteckten Schimmel?
Muffiger Geruch, dunkle Flecken oder feuchte Wände sind typische Hinweise. Ein Schnelltest schafft Gewissheit.
Welche Reinigungsmittel helfen wirklich?
Professionelle Produkte wie die MELLERUD-Reiniger wirken zuverlässig.
Wie beuge ich Schimmel langfristig vor?
Richtiges Lüften, gleichmäßiges Heizen und Reduktion von Feuchtigkeit sind entscheidend.
Kann ich Schimmel selbst entfernen?
Ja, bei kleinen Bereichen und geeigneten Mitteln. Bei großem Befall sollte ein Fachmann hinzugezogen werden.
Möchten Sie Schimmel sicher und nachhaltig entfernen?
Entdecken Sie unsere spezialisierten Produkte auf mellerud.de –
für ein hygienisches, gesundes und wohltuendes Zuhause.